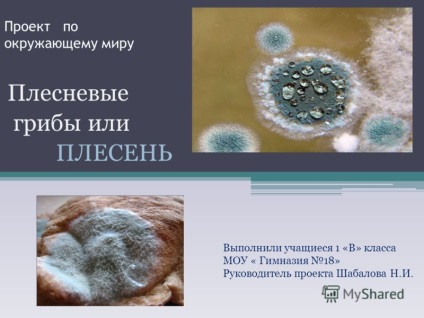

A bemutató a projekt a környező világ, penész vagy penész diákok elkészült 1 - A
Előadás témája: „Project külvilág Formák és penész Végzett diákok 1 db” B „osztályú Memorandum” College 18 „projekt vezetője Shabalova NI” - átirata:
1 projekt a környező világ Formák és penész Végzett diákok 1 db „B” osztályú Memorandum „College 18” Head Shabalova Project NI
2. A projekt célja az: elméleti és kísérleti vizsgálata kísérleti penész. Tárgy: Forma kísérleti munkát. Termesztése penészgombák élelmiszerek és nyomon követi annak növekedését. A projekt céljai 1.Rassmotret szerepe penész és annak hatása az emberi életre. 2. feltételeinek megteremtése a kísérlet, hogy tanulmányozza a penész. 3. Grow a vizsgálat tárgya a háztartásokban különböző élelmiszerek

3 Mould Ő megjelent a Földön 200 millió évvel ezelőtt. Azóta megöli és megment a haláltól. Ez az úgynevezett Ördög kenyeret, és köpni Istent. Hihetetlenül szép, de ez undorító. Ez mindenhol jelen van és kiirthatatlan. Ez szerepel a szent könyvek, és a kétségbeesés a tudósok.

4 Formák (öntőformák) - egy különleges birodalmában élő természet. Képviselői ennek Királyság egyaránt hasonlóságok és különbségek a baktériumok, növények és állatok. Úgy tartják, hogy az ideális feltételeket a megjelenése és elterjedése a penész - hőmérséklet plusz 20 0 C és a relatív páratartalom 95% felett.

5 Hasznos penész penész felhasználtak különböző gyógyszereket. Az öntőforma előállításához alkalmazott különböző élelmiszer-ipari termékek: bor, sör, kenyér, sajt, savanyú káposzta.

6. Vannak rossz penész. Azt is elpusztítani beton, tégla és stukkó. Ő repül a levegőben, és rontja az étel.
7. A tanulók 1 db „B” osztályú végeztünk kísérleteket a termesztés penész a lakásban. Meshcheryakov Éva 1 nap 2 nap 4 nap
